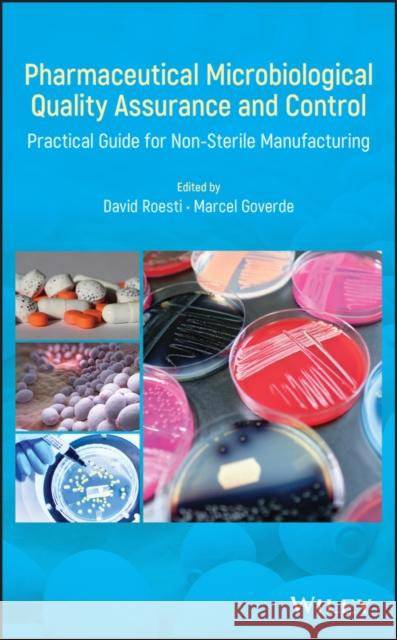
Pharmaceutical Microbiological Quality Assurance and Control: Practical Guide for Non-Sterile Manufacturing Roesti, David 9781119356073 Wiley - książka

ISBN-13: 9781119356073 / Angielski / Twarda / 2020 / 592 str.
ISBN-13: 9781119356073 / Angielski / Twarda / 2020 / 592 str.
Editors xixList of Contributors xxiPreface xxviiForeword xxxiiiAcknowledgments xxxv1 Microbiological Control Strategy 1David Roesti and Marcel Goverde1.1 Introduction 11.2 Overview of a Microbial Control Strategy Program 21.3 Main Factors to Be Controlled 41.4 Conclusion 18Bibliography 182 Microbial Contamination Risk Assessment in Non-sterile Drug Product Manufacturing and Risk Mitigation 23Tony Cundell2.1 Introduction 242.2 Regulatory, Compendia, and Industry Guidance 242.3 Putting into Perspective the Microbiological Risk Associated with Non-sterile Products 252.4 Risk Assessment Tools 292.5 Organizational Risk Management Maturity 352.6 Hierarchy of Risks 352.7 Effect of Product Attributes 462.8 Emerging Manufacturing Technologies 482.9 A Case History 522.10 Conclusions 53Bibliography 533 Qualification of Microbiological Laboratory Personnel and Equipment 57Robert Schwarz3.1 Introduction 573.2 Reasons, Requirements, and Strategies for Qualification 583.3 Critical Aspects of Microbiological Methods 683.4 Practical Examples for Qualification of Laboratory Personnel 72Acknowledgments 76Bibliography 764 Introduction to Culture Media in Pharmaceutical Microbiology for Non-sterile Products 79Marion Louis, Laurent Leblanc, and Félix A. Montero Julian4.1 Introduction 804.2 Culture Media Challenges and Development 834.3 Importance of Culture Media for Patient Safety 834.4 Culture Media are all Different 834.5 Innovation in Regard to Culture Media 914.6 Quality Controls 924.7 Culture Media Troubleshooting 984.8 Conclusion 103Bibliography 1035 Microbiological Examination of Non-sterile Final Dosage Forms and Raw Material Including Acceptance Criteria and Testing Frequency 105David Roesti5.1 Microbiological Acceptance Criteria 1065.2 Testing Frequency 1125.3 Procedure if Microbial Growth Occurs in Routine Testing 1175.4 Sampling 1175.5 Nutrient Medium Controls 1205.6 Test Method Overview 1255.7 Verification of the Suitability of the Method 1275.8 Microbiological Examination of Non-sterile Products 1425.9 Elements to Consider for Raw Data Sheets 148Acknowledgments 149Bibliography 1496 Microbial Requirements and Testing of Primary Packaging 153Marcel Goverde6.1 Introduction 1546.2 Guidelines and Literature 1616.3 Acceptance Criteria and Testing Frequency 1646.4 Test Methods 1706.5 Suitability Test 1746.6 OOS Procedure 1776.7 Examples of OOS or OOE Cases 1786.8 Conclusion 184Bibliography 1857 Utilities Design and Testing 189Tim Sandle7.1 Introduction 1907.2 Defining, Developing, and Maintaining Utilities 1917.3 Review of Critical Utilities 1987.4 Conclusion 226Bibliography 2278 Microbiological Environmental Monitoring 231Alexandra Stärk8.1 Introduction 2328.2 Microbiological Control Strategy 2338.3 Cleanliness Zoning Concept for Non-sterile Products 2338.4 Microbiological Environmental Monitoring Strategy 2348.5 Microbiological Environmental Monitoring Methods 2358.6 Method Validations and Suitability Tests for Microbiological Environmental Monitoring 2388.7 Initial Validation of Cleanrooms and Production Equipment 2448.8 Definition of a Microbiological Environmental Routine Monitoring Program 2468.9 Microbiological Environmental Monitoring: Examples for Users 2538.10 Conclusion 261Bibliography 2629 Identification of Microorganisms 265Christine E. Farrance9.1 Introduction 2669.2 History and Challenges of Bacterial Taxonomy and Classification 2689.3 History and Challenges of Fungal Taxonomy and Classification 2769.4 Current Identification Technologies 2799.5 Strengths and Weaknesses with Each Categorical Method 3069.6 Case Studies from a Contract Testing Lab 3099.7 Conclusion 313Bibliography 31410 Calculating Alert Levels and Trending of Microbiological Data 329David Roesti10.1 Introduction 33010.2 Goal of the Chapter 33210.3 Alert Levels Based on Historical Data 33210.4 Trending 35510.5 Conclusion 367Acknowledgments 367Bibliography 36711 Exclusion of Objectionable Microorganisms from Non-sterile Pharmaceutical Drug Products 371Tony Cundell11.1 Introduction 37211.2 What is an Objectionable Microorganism? 37411.3 Screening for Objectionable Microorganisms 38311.4 Risk-Based Microbial Testing of Non-sterile Drug Products 38811.5 Sources of Objectionable Microorganisms 38911.6 Risk Assessment to Determine if a Microorganism is Objectionable in a Non-sterile Drug Product 39211.7 Case Histories 39511.8 Conclusions 398Bibliography 39912 Data Integrity and Microbiological Excursion Handling 401David Roesti and Marcel Goverde12.1 Data Integrity 40112.2 General Concept for Microbiological Excursion 41012.3 Considerations for Excursions 420Bibliography 42713 Rapid Microbiological Methods 429Michael J. Miller13.1 Introduction 42913.2 The Current State of Microbiology Testing 43113.3 Rapid Microbiological Methods 43213.4 Applications for Non-sterile Pharmaceutical Drug Products 43313.5 Technology Review 43513.6 Validating Rapid Microbiological Methods 44713.7 Developing a Business Case for Rapid Methods 45413.8 Summary 455Bibliography 45614 Validation of a Rapid Microbiological Method for the Microbiological Examination of Non-sterile and Nonfilterable Drug Products, APIs, and Excipients 459Oliver Gordon and David Roesti14.1 Introduction 46014.2 Method Validation 46214.3 Suitability Test (Product-Specific Method Validation) 47914.4 Discussion 48314.5 Conclusion 486Acknowledgments 486Bibliography 48715 An Ex-Regulator's View of the Microbiology QA/QC Functions in the US Pharmaceutical Industries 489David Hussong15.1 Foods, Drugs, and Quality 48915.2 Why Microbes Confound a Census 49215.3 Microbiological QA Decisions 49415.4 Who Has Responsibility for Quality? 49515.5 Product and Process Planning 49615.6 Quality and Documentation in Drug Manufacturing 49915.7 Summary 500Bibliography 50116 Practical Guide for Microbiological QA/QC of Non-sterile Pharmaceuticals Manufacturing for EU 505Ina Bach16.1 Introduction 50516.2 General Requirements 50616.3 Audit Assessment Tools of a Microbiological Laboratory 50816.4 Regulatory Audits in the Microbiology Department 51416.5 Conclusions 516Bibliography 51717 Which Microbiological Tests Can Better Be Performed In-house and What Can Be Easily Outsourced 519Thomas Meindl and Ingo Grimm17.1 Introduction 51917.2 Advantages and Disadvantages of Outsourcing 52217.3 Business Case and Hidden Costs 52417.4 Hidden Costs 52817.5 Quality Agreement Between the Contract Laboratory and the Requesting Company 52917.6 Auditing Contract Laboratories 53217.7 A Case History 53217.8 Conclusions 535Bibliography 536Index 539
David Roesti, PhD, works at Novartis Pharma AG in Stein, Switzerland, and is responsible for defining the microbial control strategy at the site and is a global subject matter expert in microbiology for the Novartis group. He is also is an elected member of the General Chapters Microbiology Expert Committee of the Unites States Pharmacopoeia 2015-2020 revision cycle.Marcel Goverde, PhD, runs MGP Consulting GmbH for consulting, training and project management in GMP-relevant areas with a focus on microbiology, hygiene and deviation management. He is the Swiss expert in the EDQM group for Modern Microbiological Methods since 2003, which was then integrated into Group 1 (Microbiological Methods and Statistical Analysis) in 2015.
1997-2026 DolnySlask.com Agencja Internetowa